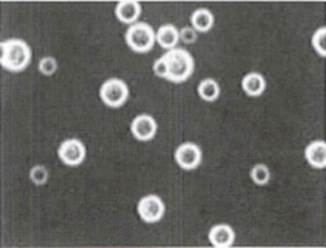

크립토코쿠스증 (Cryptococcosis)
기본 개념
크립토코쿠스증 (Cryptococcosis)
C. neoformans, C. gattii
주로 후천면역결핍증후군 등 면역저하자에게 중추신경계 감염 (C. neoformans)
수막염 : 세균성 수막염과 달리 몇 주에 걸쳐 증상 (두통, 발열, 수막자극증 등)
폐렴 : 기침, 가래증가, 흉통
진단: Direct microscopy (객담 India ink staining)
치료
Pulmonary cryptococcosis : Fluconazole
CNS cryptococcosis : Amphotericin B + Flucytosine
0개의 글
글 작성
** 제목만 보더라도 어떤 내용인지 알 수 있도록 완성된 문장으로 작성해주세요.
예시) 초음파 (X) → 초음파 사진에서 PDA 소견을 어떻게 알 수 있나요? (O)